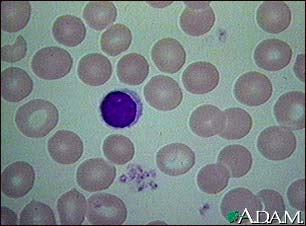
Red blood cells, normal Red blood cells, normal

| Skip navigation | ||
![]() |
![]() | ![]() |
|
|
||
Red blood cells, normal
This photomicrograph shows normal red blood cells (RBCs) as seen in the microscope after staining.
Update Date: 5/1/2006 Updated by: Michael C. Milone, M.D., Ph.D., Department of Pathology and Laboratory Medicine, University of Pennsylvania Medical Center, Philadelphia, PA.

| Home | Health Topics | Drugs & Supplements | Encyclopedia | Dictionary | News | Directories | Other Resources | |
| Copyright | Privacy | Accessibility | Quality Guidelines U.S. National Library of Medicine, 8600 Rockville Pike, Bethesda, MD 20894 National Institutes of Health | Department of Health & Human Services |
Page last updated: 02 January 2008 |